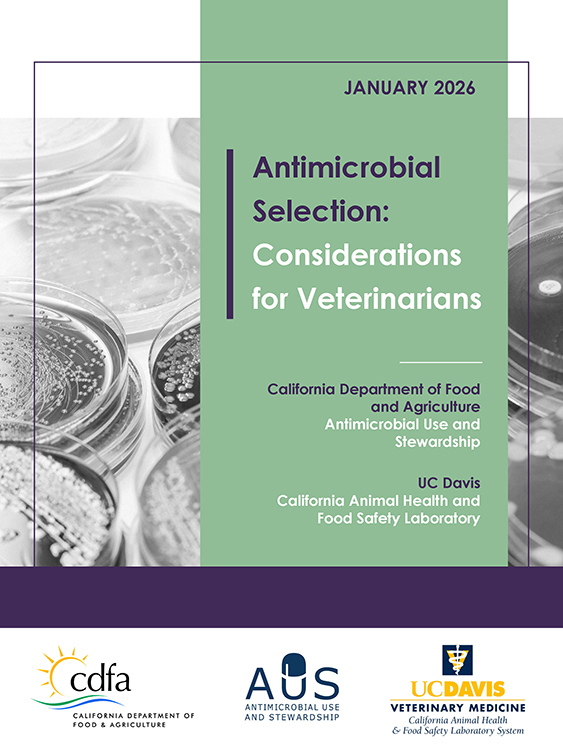
Antimicrobial Selection: Considerations for Veterinarians thumbnail

Antimicrobial Use & Stewardship
Antimicrobial Use & Stewardship
Program Updates
Since the introduction of antimicrobials in the 1940s, illness and deaths in both people and animals from infectious diseases have been greatly reduced. Unfortunately, as these drugs have been used so widely for so long to treat both humans and animals, many of the germs (bacteria) are adapting and are no longer vulnerable, making them resistant to these wonder drugs.
A coordinated effort by physicians, veterinarians, individual patients, animal caretakers and producers is essential in order to preserve the efficacy of antimicrobial drugs. CDFA’s Antimicrobial Use & Stewardship program provides the education and tools for veterinarians and producers to make decisions regarding disease prevention and judicious use of antimicrobials in livestock. The intent is to uphold best animal health practices in order to provide a safe, secure, and bountiful food supply, while reducing the emergence of antimicrobial resistance.
Veterinarians & Livestock Producers are:
- Working together to combat antibiotic resistance through judicious use of antibiotics
- Optimizing animal health and welfare
- Evaluating trends and practices to identify opportunities to reduce or optimize antibiotic use
- Required to have a valid Veterinarian-Client-Patient relationship
Veterinarians may prescribe antibiotics for the treatment, control or, in some cases, prevention of disease.
Effective January 1, 2018, “regular pattern” use for disease prevention is prohibited by law.
| How is the CA law different from the Federal law? | ||
|---|---|---|
| Source |
![]() Federal Law
|
![]() California Law
|
| Drugs | Medically Important Antibiotics (GFI #152) | Same |
| Formulations | Medicated feed and water | All (injectable, intra-mammary, feed, etc.) |
| Veterinary Oversight | Yes, VFD for medicated feed or Rx for water drugs | Yes, VFD for medicated feed or Rx for all others |
| Medical Indications | Treatment, control, and prevention | Treatment, control, and in some cases, prevention |
| Limitations | Not for growth promotion (GPA) or feed efficiency | No GPA or “regular pattern” preventative use |
| Effective Date | January 1, 2017 | January 1, 2018 |
Antimicrobial Resistance (AMR)
What causes antibiotic resistance?
Explore how bacteria become resistant to antibiotics and turn into superbugs, and what scientists are doing to stop it. (4:34)